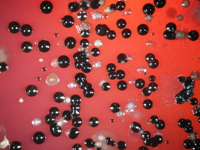
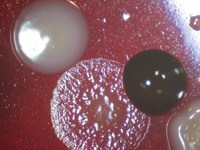
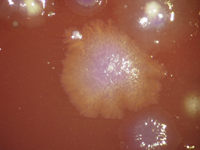

A diez años de su creación, el Laboratorio de Microbiología de la Facultad de Odontología de la Universidad de Chile ofrece importantes servicios que apoyan la labor del clínico en el diagnóstico de diversas patologías bucales, tales como caries y enfermedad periodontal.
El equipo de profesionales del Laboratorio está liderado por el Prof. Dr. Jorge Huerta Miranda, Jefe del Área de Microbiología, junto a las Profesoras TM Nora Silva Steffens, TM Leyla Gómez Carranza, Dra. Patricia Palma Fluxá y la Prof. Marta Gajardo Ramírez.
Luego de una estadía de la Prof. Marta Gajardo en los Laboratorios de la Casa Dental Dentaid en Barcelona (España), donde trabajó con microbiólogos dedicados al cultivo de anaerobios bucales, la académica regresó a Chile y entrenó a sus colegas con el propósito de implementar el servicio en la Facultad de Odontología.
Es así como el Servicio de Anaerobios Bucales del Laboratorio de Microbiología surgió, en 1998, al alero de un Proyecto con Excedentes, lo que permitió equiparlo con instrumentos e insumos necesarios para iniciar la marcha del Servicio, cuyo objetivo es apoyar al clínico en el diagnóstico y tratamiento de patologías infecciosas bucales a través del Informe Microbiológico.
Las enfermedades infecciosas bucales se caracterizan porque su agente etiológico no es un microorganismo aislado, sino una microbiota compleja y diversa de especies bacterianas organizadas como biopelícula.
El paciente con periodontitis presenta, entre el diente y la encía, un saco denominado saco periodontal, el que está infectado por una microbiota muy característica y presente en gran cantidad. La mayoría corresponde a bacterias anaeróbicas estrictas, también conocidas como bacterias fastidiosas, por su dificultad en el cultivo.
El cultivo microbiológico, realizado en el Laboratorio, permite obtener información sobre el recuento o cantidad total de bacterias cultivables, presentes en el saco periodontal, y sobre el porcentaje relativo de 9 patógenos periodontales.
Además, el análisis informa sobre la presencia de bacterias inusuales las que, eventualmente, podrían provocar refractariedad al tratamiento o un repoblamiento por la microbiota. Próximamente, anticipó la Prof. Gajardo, "se incorporará al informe, un estudio de sensibilidad a los antibióticos de las especies aisladas".
Al servicio del control microbiológico
Si bien la tecnología molecular actual aplica la técnica del PCR para investigar la presencia de un patógeno en particular, "el servicio de análisis microbiológico mediante cultivo, exclusivo de la Facultad de Odontología, entrega información sobre la microbiota total y sobre el porcentaje de patógenos periodontales, permite detectar bacterias inusuales y realizar un antibiograma", explicó la Prof. Gajardo.
El Laboratorio de Microbiología, que en su primera década de existencia ha analizado más de 500 muestras subgingivales, cuenta hoy con un Gabinete de Bioseguridad clase IIA emplazado en una pieza semi-aislada que permite un ambiente con menor contaminación; además, cuenta con dos lupas estereoscópica y un microscopio, imprescindible para efectuar los análisis macroscópico y microscópico, respectivamente, pasos esenciales en el diagnóstico microbiológico.
"Lupas y microscopio están equipados con una cámara fotográfica que permite registrar lo que observamos en cada muestra y como está conectada al computador, procesar y almacenar la información obtenida. Tenemos también incubadores a 36º C, autoclaves, horno Pasteur, refrigeradores de -20º para mantención de los aislados que nos interesa conservar con fines de investigación", describió la Prof. Gajardo.
Cabe destacar que el Laboratorio realiza y apoya diversos Proyectos de Investigación sobre Prevalencia y caracterización de patógenos periodontales en la población. Chilena, "Constatamos por ejemplo que, a diferencia de los que ocurre en otros países, en Chile, la especie Porphyromonas gingivalis es la que predomina en los cuadros de periodontitis agresiva".
Actualmente las especialistas realizan un registro de patógenos periodontales en niños, pues se ha observado "que los patógenos periodontales comienzan a colonizar antes de lo que uno pensaba, por lo tanto la prevención debe iniciarse con anterioridad, información que necesitamos ponerla en manos de los clínicos para que la consideren al momento de diagnosticar, tratar y hacer prevención".
La Prof. Gajardo advirtió que el control microbiológico "se ha recomendado mucho en el extranjero para los pacientes que serán sometidos a implantes, porque se ha visto que muchos de los fracasos en estos procedimientos se debe al rechazo producido por una microbiota previamente establecida y que, al no ser identificada, no pudo ser erradicada o, al menos, reducida".
El servicio de Análisis Microbiológico se encuentra disponible para toda la comunidad odontológica del país y tiene un costo de $45.000 por examen, cuando proviene de un especialista externo a la Facultad de Odontología y de $ 25.000, cuando se trata de un clínico de nuestra Facultad.
La Microbiología ha demostrado que los patógenos que están en la cavidad bucal son capaces de emigrar al resto del organismo y constituir un foco de infecciones sistémicas. Por ejemplo, señaló la Prof. Gajardo, "Porphyromonas gingivalis es un patógeno que se ha visto asociados a cardiopatías y otras enfermedades de riesgo, tema que está siendo abordado por la Prof. Nora Silva S. y Prof. Leyla Gómez C. También hemos investigado, en colaboración con el área de Periodoncia de esta Facultad y Ginecología del Hospital Paula Jaraquemada, la presencia de patógenos periodontales en el líquido amniótico de mujeres con síntomas de parto prematuro", confirmó la académica.